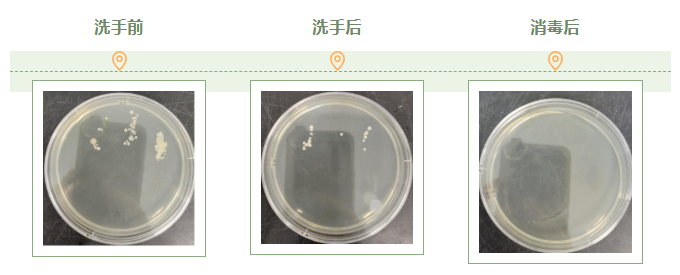
图片1.png 图片1.png

【儿研所儿医说】你的手真的洗干净了吗?
洗手是最简单、最有效的个人卫生习惯之一,能够有效地去除手上的污垢、细菌和病毒,降低疾病传播的风险。因此,养成良好的洗手习惯对于维护个人健康具有十分重要的意义。我们通过一个简单的实验看一下,洗手前后及消毒后手部微生物的变化情况:
取样方法:手掌伸直,手指充分接触固体培养基平板。
第一步:不洗手取样。
第二步:用洗手液洗手(六步洗手法)并晾干后取样。
第三步:75%酒精消毒后取样。
第四步:培养,将取样后的三个平板放入30~35℃培养箱中,培养24小时。
通过培养结果(见下图)可以看出,洗手后菌落明显减少,消毒后平板上无菌落生长,生活中我们是不是应该好好洗手消毒呢?洗手前洗手后消毒后。